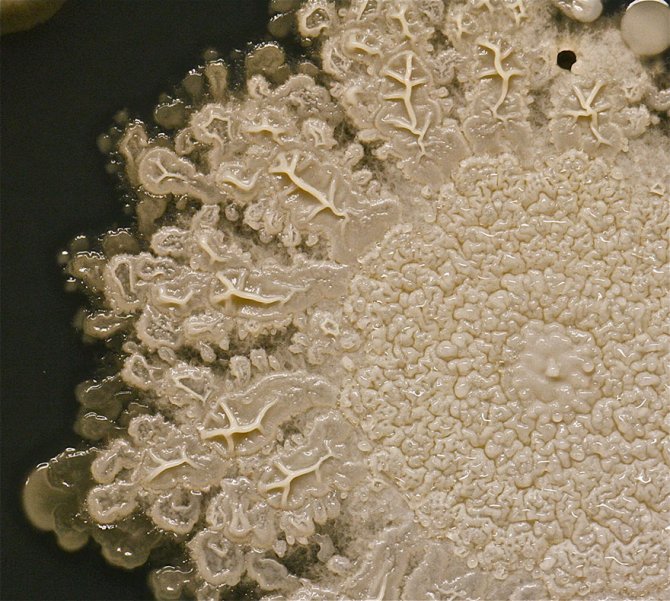

Copyright © 2025 Dailybest.it proprietà e gestione multimediale di Too Bee Srl - Via Cavour 310 - 00184 Roma - P.Iva 17773611003 - Questo blog non è una testata giornalistica, in quanto viene aggiornato senza alcuna periodicità. Non può pertanto considerarsi un prodotto editoriale ai sensi della legge n. 62 del 07.03.2001
Copyright © 2025 Dailybest.it proprietà e gestione multimediale di Too Bee Srl - Via Cavour 310 - 00184 Roma - P.Iva 17773611003 - Questo blog non è una testata giornalistica, in quanto viene aggiornato senza alcuna periodicità. Non può pertanto considerarsi un prodotto editoriale ai sensi della legge n. 62 del 07.03.2001